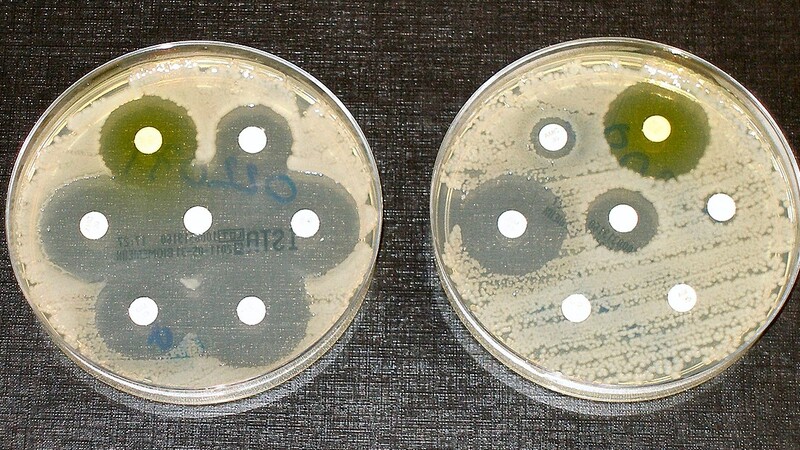

Спецраздел
Специальный проект урологического информационного портала UroWeb.ru
и фармацевтической компании SH PHARMA LTD
и фармацевтической компании SH PHARMA LTD
Сексуальное и репродуктивное здоровье
Мочекаменная болезнь
Синдром нижних мочевых путей
Урогенитальные инфекции
Урогенитальные инфекции
Информационный раздел об урогенитальных инфекциях
Новости о ИМП
Дата публикации: 08.02.2020
332419